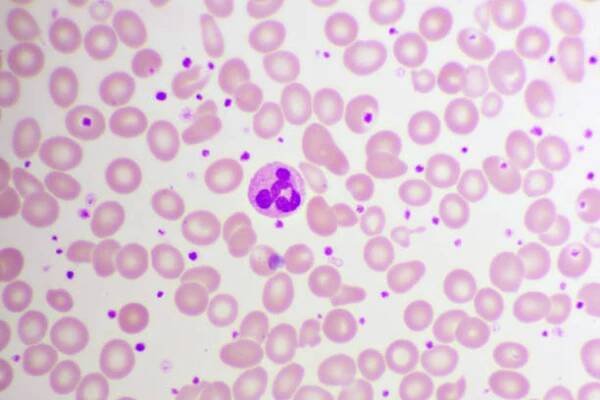

Trombocytóza je abnormální stav, který se vyznačuje dočasně zvýšeným počtem krevních destiček (odborně trombocytů) v krvi. Trombocytóza je obvykle způsobena jiným onemocněním nebo abnormálním stavem, a vyskytuje se častěji než trombocytemie.
Trombocytopenie – Wikipedie
Jedná se o stav, kdy množství trombocytů v periferní krvi klesne pod 10×10⁹/l. Podle příčiny onemocnění se trombocytopenie dělí na:
Neobsahuje trombocytózaMusí obsahovat trombocytóza
Krevní destičky neboli trombocyty - jak zajistit správnou…
Co jíst, aby se zvýšil počet krevních destiček? Jak zvýšit nízkou hladinu krevních destiček? To a další informace naleznete v tomto článku.
trombocyty (krevní destičky) » Linkos.cz
Krevní destičky (trombocyty) jsou "útržky" buněk – megakaryocytů. Mají na starosti srážení krve a udržení cév bez trhlin. Jejich normální koncentrace se pohybuje kolem 200 až 400 miliard v litru krve.
Neobsahuje trombocytózaMusí obsahovat trombocytóza
Trombocyt | Medicína, nemoci, studium na 1. LF UK
Trombocyty (krevní destičky) jsou bezjaderné krevní elementy, které hrají roli ve srážení krve. V krvi se jich nachází asi 150-350 x 109 na litr. Běžná délka života trombocytu je asi 9 dnů.
Neobsahuje trombocytózaMusí obsahovat trombocytóza
Trombóza – příznaky, rizika, prevence a léčba | Pilulka.cz
Komplexní a podrobný průvodce trombózou. Od rozpoznání příznaků přes možnosti léčby, až po preventivní opatření. Získáte všechny důležité informace o tomto závažném zdravotním problému.
Neobsahuje trombocytózaMusí obsahovat trombocytóza
Trombocytopémie
Trombocyty neboli krevní destičky jsou bezjaderné formované krevní elementy, které mají nezastupitelnou úlohu při zástavě krvácení (hemostáze).
Trombocyty neboli krevní destičky: Jaké důležité funkce…
Zdravě.cz - zdravý životní styl, informace o nemocech a jejich léčbě, těhotenství a péče o dítě, hubnutí, alternativní medicína, sport a relaxace, vztahy a sex
Trombocytopenie – WikiSkripta
Internetové studijní materiály pro studenty českých a slovenských lékařských fakult.
Neobsahuje trombocytózaMusí obsahovat trombocytóza
odkazuje na služby nejen od Seznam.cz.
© 1996–2025 Seznam.cz, a.s.